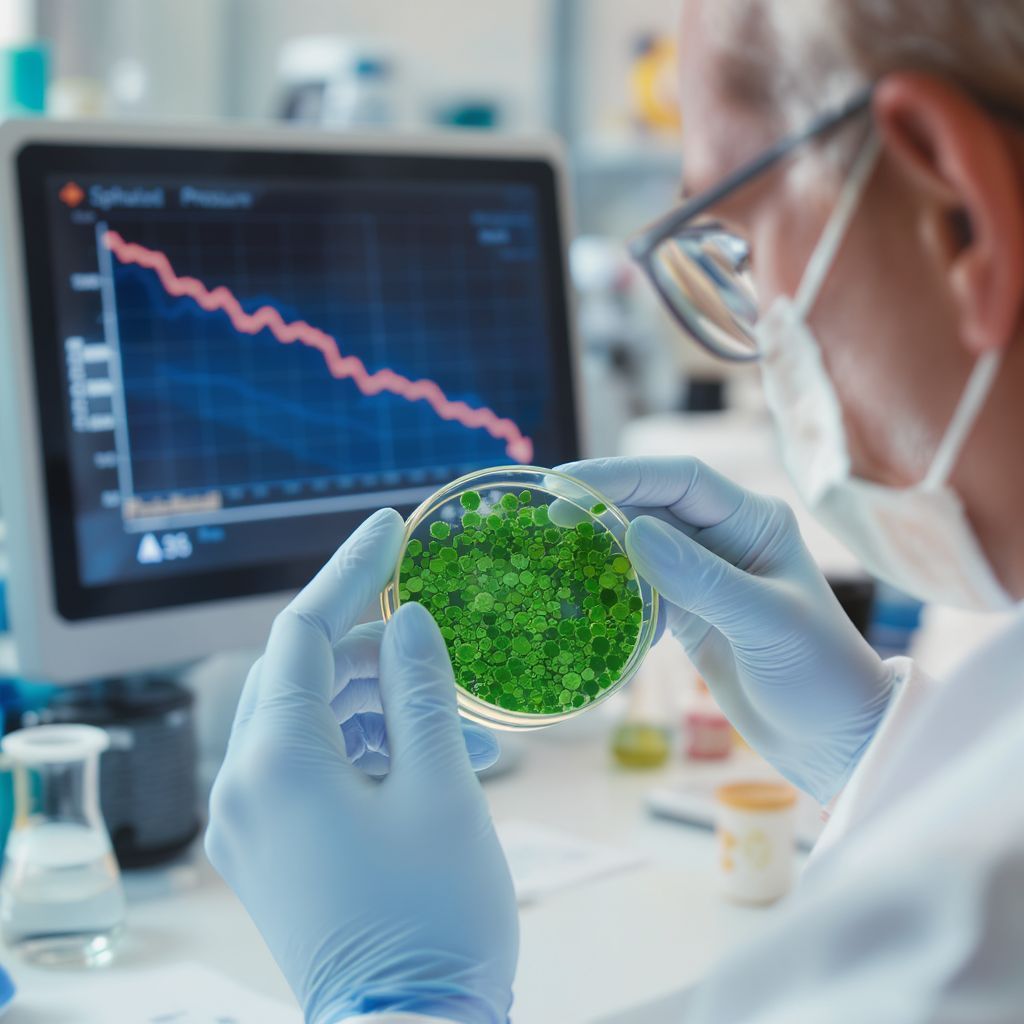
A nitrogén-monoxid elősegíti az erek tágulását, csökkentve a vérnyomást.

A modern életvitel számos kihívást tartogat egészségünk számára, és ezek közül az egyik legelterjedtebb, mégis gyakran észrevétlen veszély a magas vérnyomás, orvosi nevén hipertónia. Ez a csendes gyilkos évente emberek millióinak életét keseríti meg, növelve a szívroham, a stroke, a veseelégtelenség és más súlyos kardiovaszkuláris betegségek kockázatát. Miközben a gyógyszeres kezelés sok esetben elengedhetetlen, egyre többen keresik a természetes, kiegészítő módszereket, amelyek segíthetnek a vérnyomás optimális szinten tartásában és az általános jóllét megőrzésében.
Ebben a törekvésben a természet patikája számos kincset kínál, amelyek közül az egyik legígéretesebb és legkutatottabb a spirulina. Ez a mikroszkopikus kék-zöld alga, amelyet már évezredek óta fogyasztanak különböző kultúrák, az elmúlt évtizedekben vált igazán ismertté kivételes tápanyagprofilja és potenciális egészségügyi előnyei miatt. De vajon hogyan képes ez az apró organizmus hozzájárulni a vérnyomás csökkentéséhez, és milyen mechanizmusok állnak a hatása mögött? Merüljünk el a spirulina lenyűgöző világában, és fedezzük fel, miként segíthet a szív- és érrendszer egészségének megőrzésében.
A magas vérnyomás csendes veszélye és a természetes megoldások keresése
A magas vérnyomás definíció szerint az az állapot, amikor az erekben a vér áramlásakor tartósan megnő a nyomás. Ez a megnövekedett terhelés idővel károsítja az érfalakat, vastagabbá és kevésbé rugalmassá teszi azokat, ami tovább nehezíti a szív munkáját. A hipertónia gyakran tünetmentes marad hosszú éveken át, ezért is nevezik „csendes gyilkosnak”, hiszen mire a tünetek jelentkeznek, a károsodás már jelentős lehet.
A modern orvostudomány hatékony gyógyszereket kínál a vérnyomás szabályozására, ám sokan idegenkednek a hosszú távú gyógyszerszedéstől, vagy egyszerűen csak szeretnék kiegészíteni a terápiát természetes módszerekkel. A hangsúly egyre inkább a preventív életmódváltáson és a természetes alapanyagú étrend-kiegészítőkön van, amelyek mellékhatások nélkül támogathatják a szervezet öngyógyító folyamatait. Itt lép be a képbe a spirulina, mint egy olyan szuperélelmiszer, amely komplex módon képes hozzájárulni a vérnyomás optimalizálásához.
A magas vérnyomás nem csupán egy szám a mérőórán, hanem egy összetett állapot, amely a szív- és érrendszer egészségét alapjaiban befolyásolja. A természetes támogatás keresése egyre inkább előtérbe kerül a hosszú távú jóllét megőrzésében.
Mi is az a spirulina? Egy ősi szuperélelmiszer bemutatása
A spirulina valójában nem alga, hanem egy cianobaktérium, más néven kék-zöld alga, amely spirális formájáról kapta a nevét. Ez az ősi mikroorganizmus már több mint 3,5 milliárd éve létezik a Földön, és édesvízi tavakban, valamint sós vizű tavakban tenyészik, különösen meleg, szubtrópusi éghajlaton. Az aztékok és más őslakos kultúrák már évezredekkel ezelőtt felismerték táplálkozási értékét, és rendszeresen fogyasztották.
A spirulina a 20. század második felében vált újra népszerűvé, amikor a tudósok felfedezték kivételesen gazdag tápanyagtartalmát. Az űrhajósok élelmezésében is felmerült a lehetősége, mint egy kompakt, tápanyagban dús élelmiszerforrás. Ma már világszerte termesztik ellenőrzött körülmények között, hogy biztosítsák tisztaságát és hatóanyag-tartalmát, és por, tabletta vagy kapszula formájában kapható.
A spirulina tápanyagprofilja: Miért olyan különleges?
A spirulina valóban a természet egyik legkomplexebb tápláléka, amely szinte minden nélkülözhetetlen tápanyagot tartalmaz, amire a szervezetnek szüksége van az optimális működéshez. Ez a kivételes tápanyag-sűrűség teszi lehetővé, hogy számos egészségügyi előnnyel járjon, beleértve a vérnyomás szabályozását is.
Először is, a spirulina magas fehérjetartalmú, akár 60-70%-ban is állhat fehérjéből, ami jelentősen több, mint a marhahúsé vagy a szójáé. Ezek a fehérjék mind a nyolc esszenciális aminosavat tartalmazzák, így teljes értékű fehérjeforrásnak számítanak. A fehérjék kulcsfontosságúak az izmok, enzimek, hormonok építéséhez és számos biokémiai folyamathoz, amelyek közvetve hozzájárulnak a szív- és érrendszeri egészséghez.
Ezen túlmenően, rendkívül gazdag vitaminokban és ásványi anyagokban. Jelentős mennyiségben tartalmaz B-vitaminokat (különösen B1, B2, B3, B6), amelyek részt vesznek az energiatermelésben és az idegrendszer működésében. Kiemelkedő a K-vitamin tartalma is, amely fontos a véralvadáshoz és a csontok egészségéhez. Az ásványi anyagok közül megtalálható benne a vas, a magnézium, a kálium, a kalcium, a cink és a szelén, amelyek mindegyike alapvető fontosságú a vérnyomás szabályozásában és a szív egészséges működésében.
A spirulina igazi ereje azonban az antioxidánsokban rejlik. Különösen kiemelkedő a fikocianin nevű pigment, amely adja a spirulina jellegzetes kék-zöld színét, és erőteljes antioxidáns, valamint gyulladáscsökkentő tulajdonságokkal bír. Ezenkívül tartalmaz béta-karotint (az A-vitamin előanyaga), zeaxantint és más karotinoidokat, amelyek szintén hatékonyan semlegesítik a szabadgyököket. A klorofill, amely szintén nagy mennyiségben van jelen, hozzájárul a méregtelenítéshez és a vér oxigénszállító kapacitásának javításához.
Végül, de nem utolsósorban, a spirulina esszenciális zsírsavakat is tartalmaz, mint például a gamma-linolénsav (GLA), amely egy omega-6 zsírsav. Bár az omega-6 zsírsavak hírneve vegyes, a GLA-nak gyulladáscsökkentő hatása van, és szerepet játszhat az érrendszeri egészség fenntartásában.
| Tápanyagcsoport | Főbb összetevők | Kardiovaszkuláris hatás |
|---|---|---|
| Fehérjék | Esszenciális aminosavak | Építőkövek, enzimműködés támogatása |
| Vitaminok | B1, B2, B3, B6, K, A (béta-karotin) | Energiatermelés, véralvadás, antioxidáns védelem |
| Ásványi anyagok | Vas, magnézium, kálium, kalcium, cink, szelén | Vérnyomás szabályozás, elektrolit egyensúly, szívritmus |
| Antioxidánsok | Fikocianin, béta-karotin, zeaxantin, klorofill | Szabadgyök semlegesítés, gyulladáscsökkentés, érfalvédelem |
| Esszenciális zsírsavak | Gamma-linolénsav (GLA) | Gyulladáscsökkentés, érrendszeri támogatás |
A nitrogén-monoxid szerepe a vérnyomás szabályozásában és a spirulina kapcsolata
A nitrogén-monoxid (NO) egy apró, de rendkívül fontos molekula, amely kulcsszerepet játszik a vérnyomás szabályozásában és az érrendszer egészségének fenntartásában. Az NO az erek belső falát borító sejtek, az endotélsejtek által termelődik, és elsődleges feladata az erek ellazítása, azaz a vazodilatáció előidézése. Amikor az erek ellazulnak és kitágulnak, a vérnyomás természetes módon csökken, mivel a vér könnyebben áramlik.
A spirulina több mechanizmuson keresztül is hozzájárulhat a nitrogén-monoxid termelésének és biológiai hasznosulásának fokozásához. Az egyik legfontosabb hatóanyag a már említett fikocianin, amelyről kimutatták, hogy képes serkenteni az endoteliális nitrogén-monoxid szintáz (eNOS) enzim aktivitását. Ez az enzim felelős az NO termeléséért az érfalakban, így a fokozott aktivitás több NO felszabadulásához vezet.
Emellett a spirulina gazdag L-arginin nevű aminosavban is, amely közvetlen előanyaga a nitrogén-monoxidnak. Bár a szervezetünk képes L-arginint előállítani, a kiegészítő bevitel segíthet fenntartani az optimális NO-szintet, különösen stresszes állapotokban vagy magasabb igény esetén. A spirulina antioxidáns tartalma is hozzájárul az NO védelméhez, mivel a szabadgyökök gyorsan lebontják ezt a molekulát, csökkentve annak hatékonyságát. Az antioxidánsok semlegesítésével a spirulina biztosítja, hogy a termelt NO hosszabb ideig fejthesse ki vérnyomáscsökkentő hatását.
Antioxidáns védelem és gyulladáscsökkentés: Kulcsszerep a szív egészségében
A krónikus gyulladás és az oxidatív stressz két olyan alapvető folyamat, amelyek szorosan kapcsolódnak a magas vérnyomás kialakulásához és progressziójához. Az oxidatív stressz akkor lép fel, amikor a szervezetben a szabadgyökök termelődése meghaladja az antioxidáns védekező mechanizmusok kapacitását. Ezek a szabadgyökök károsítják a sejteket, beleértve az érfalak sejtjeit is, ami gyulladáshoz és az erek merevségének növekedéséhez vezet.
A spirulina rendkívül hatékony antioxidáns és gyulladáscsökkentő tulajdonságokkal rendelkezik, főként a már említett fikocianinnak köszönhetően. Ez a vegyület nemcsak közvetlenül semlegesíti a szabadgyököket, hanem gátolja a gyulladásos mediátorok, például a ciklooxigenáz-2 (COX-2) és a lipoxigenáz (LOX) enzimek aktivitását is. Ezek az enzimek felelősek a gyulladást elősegítő molekulák termeléséért.
A spirulina egyéb antioxidánsai, mint a béta-karotin, a zeaxantin és a szuperoxid-diszmutáz (SOD) enzim szintén hozzájárulnak a sejtek védelméhez az oxidatív károsodástól. Az egészséges érfalak rugalmasak és képesek megfelelően tágulni és összehúzódni. Az oxidatív stressz és a gyulladás azonban károsítja az endotélsejteket, ami az érfalak merevségéhez és a vérnyomás emelkedéséhez vezet. A spirulina antioxidáns és gyulladáscsökkentő hatása révén hozzájárul az érfalak integritásának és rugalmasságának megőrzéséhez, ami alapvető a normális vérnyomás fenntartásához.
Az oxidatív stressz és a krónikus gyulladás a modern kor népbetegségeinek gyökere. A spirulina ereje abban rejlik, hogy ezeket a káros folyamatokat képes gátolni, így átfogó védelmet nyújt a szív- és érrendszernek.
A spirulina hatása az érfalak rugalmasságára és az endotél funkcióra
Az endotél az erek belső felületét borító egyrétegű sejtréteg, amely alapvető szerepet játszik az érrendszeri egészségben. Az endotélsejtek nem csupán passzív gátat képeznek, hanem aktívan részt vesznek a vérnyomás szabályozásában, a véralvadásban, a gyulladásos folyamatokban és az érfalak tágulásában, illetve összehúzódásában. Az endotél diszfunkció, vagyis az endotél működésének zavara, a magas vérnyomás, az érelmeszesedés és más kardiovaszkuláris betegségek egyik korai jele.
A spirulina számos összetevője révén pozitívan befolyásolhatja az endotél funkciót. A már tárgyalt nitrogén-monoxid termelés serkentése közvetlenül javítja az erek tágulási képességét. Ezenkívül a spirulina antioxidáns és gyulladáscsökkentő hatásai védelmet nyújtanak az endotélsejteknek az oxidatív stressz és a gyulladás okozta károsodásokkal szemben. A károsodott endotél kevésbé képes NO-t termelni, és hajlamosabb a gyulladásos reakciókra, ami az érfalak merevségéhez vezet.
A spirulina emellett segíthet csökkenteni a vérben keringő olyan molekulák szintjét, mint az LDL koleszterin (rossz koleszterin) oxidált formája, amely különösen káros az endotélsejtekre. Az LDL koleszterin oxidációja az érelmeszesedés egyik fő kiváltó oka, és közvetlenül hozzájárul az endotél diszfunkcióhoz. A spirulina rendszeres fogyasztása tehát hozzájárulhat az érfalak rugalmasságának megőrzéséhez és az egészséges endotél funkció fenntartásához, ami kulcsfontosságú a normális vérnyomás és a szív- és érrendszeri egészség szempontjából.
Koleszterinszint és lipidprofil javítása: Közvetett hatás a vérnyomásra
Bár a magas koleszterinszint és a magas vérnyomás két különálló egészségügyi probléma, szoros összefüggésben állnak egymással, és gyakran együtt jelentkeznek. A magas koleszterinszint, különösen a magas LDL (rossz) koleszterinszint hozzájárul az érelmeszesedés kialakulásához, amely az erek falán lerakódó plakkok képződését jelenti. Ezek a plakkok szűkítik az ereket, csökkentik azok rugalmasságát, és növelik a vérnyomást, mivel a szívnek nagyobb erővel kell pumpálnia a vért a szűkebb ereken keresztül.
A spirulina számos kutatás szerint pozitívan befolyásolhatja a lipidprofilt, azaz a vérben lévő zsírok (koleszterin és trigliceridek) szintjét. Kimutatták, hogy képes csökkenteni az összkoleszterin és az LDL koleszterin szintjét, miközben növelheti a HDL (jó) koleszterin szintjét. Ez a hatás valószínűleg a spirulina rosttartalmának, antioxidánsainak és a benne található speciális zsírsavaknak köszönhető.
A spirulina rostjai segíthetnek a koleszterin felszívódásának gátlásában a bélrendszerből, míg az antioxidánsok, mint a fikocianin, megakadályozzák az LDL koleszterin oxidációját, ami kulcsfontosságú lépés az érelmeszesedés kialakulásában. A koleszterinszint optimalizálásával a spirulina közvetett módon hozzájárul az érfalak egészségének megőrzéséhez és a vérnyomás csökkentéséhez, hiszen az egészségesebb, rugalmasabb erek könnyebben kezelik a vér áramlását.
A spirulina és a testsúlykontroll: Egy másik út a vérnyomás optimalizálásához

A túlsúly és az elhízás az egyik legjelentősebb kockázati tényező a magas vérnyomás kialakulásában. A felesleges testsúly extra terhet ró a szívre és az érrendszerre, mivel a testnek több vért kell pumpálnia a megnövekedett szövetekhez. Az elhízott egyéneknél gyakran megfigyelhető az inzulinrezisztencia és a krónikus gyulladás, amelyek szintén hozzájárulnak a vérnyomás emelkedéséhez.
A spirulina segíthet a testsúlykontrollban, ami közvetve hozzájárulhat a vérnyomás optimalizálásához. Magas fehérjetartalma révén hozzájárul a teltségérzet kialakulásához, csökkentve az étvágyat és az édesség utáni sóvárgást. A fehérjék emésztése több energiát igényel, mint a szénhidrátoké vagy a zsíroké, ami szintén segíthet a kalóriaégetésben.
Emellett a spirulina tápanyag-sűrűsége azt jelenti, hogy kevés kalória mellett is rendkívül sok esszenciális vitamint és ásványi anyagot biztosít. Ez segíthet elkerülni a tápanyaghiányt, ami gyakran hozzájárul a túlzott evéshez. A spirulina emésztést támogató hatása és a bélflóra egyensúlyára gyakorolt pozitív befolyása is szerepet játszhat a súlykontrollban, hiszen az egészséges bélrendszer hozzájárul a hatékonyabb anyagcseréhez és a jobb tápanyag-felszívódáshoz.
További egészségügyi előnyök, amelyek támogatják a szív- és érrendszeri jólétet
A spirulina vérnyomáscsökkentő és lipidprofil-javító hatásain túl számos más egészségügyi előnnyel is jár, amelyek közvetve vagy közvetlenül támogatják a szív- és érrendszeri jólétet, és hozzájárulnak az általános vitalitáshoz.
Az egyik ilyen a vércukorszint szabályozása. Egyes kutatások arra utalnak, hogy a spirulina segíthet a vércukorszint stabilizálásában, ami különösen fontos a cukorbetegek és az inzulinrezisztenciával küzdők számára. A stabil vércukorszint kulcsfontosságú az erek egészségének megőrzéséhez, mivel a magas vércukorszint károsítja az érfalakat és növeli a kardiovaszkuláris betegségek kockázatát.
A spirulina emellett erős immunmoduláló tulajdonságokkal is rendelkezik. Erősíti az immunrendszert, segítve a szervezetet a fertőzések és betegségek elleni védekezésben. Egy erős immunrendszer hozzájárul a gyulladásos folyamatok kordában tartásához, ami, mint korábban említettük, fontos a szív- és érrendszeri egészség szempontjából.
A méregtelenítés terén is kiemelkedő. A klorofill és más vegyületek segítenek a nehézfémek és toxinok eltávolításában a szervezetből. A tisztább belső környezet optimalizálja a szervek működését, beleértve a szívet és az ereket is, csökkentve a terhelést és javítva a funkciókat.
Végül, de nem utolsósorban, a spirulina hozzájárulhat a stressz csökkentéséhez és a hangulat javításához. B-vitamin tartalma támogatja az idegrendszer működését, ami közvetetten befolyásolja a vérnyomást, hiszen a krónikus stressz ismert vérnyomás-emelő tényező. Az általános energiaszint növelésével és a vitalitás fokozásával segíthet a mindennapi kihívások kezelésében, ami szintén hozzájárul a stressz szintjének alacsonyan tartásához.
A spirulina nem csupán egy vérnyomáscsökkentő csodaszer, hanem egy komplex szuperélelmiszer, amely a test számos rendszerét támogatja, holisztikus megközelítést kínálva az egészség megőrzéséhez.
Hogyan illesszük be a spirulinát az étrendünkbe? Adagolás és formák
A spirulina beillesztése a mindennapi étrendbe rendkívül egyszerű, mivel többféle formában is kapható, és könnyen adaptálható a különböző életmódokhoz. A leggyakoribb formák a por, a tabletta és a kapszula.
A spirulina por a legsokoldalúbb forma. Könnyen hozzáadható turmixokhoz, gyümölcslevekhez, joghurthoz, salátaöntetekhez vagy akár házi készítésű energiaszeletekhez. Fontos, hogy ne hevítsük túl, hogy megőrizze tápanyagértékét. Kezdetben érdemes kis adaggal (pl. 1 teáskanál/nap) kezdeni, majd fokozatosan növelni az adagot, ahogy a szervezet hozzászokik. Az ajánlott napi adag általában 3-5 gramm, de egyes esetekben akár 10 gramm is lehet, a célzott hatástól és az egyéni toleranciától függően.
A spirulina tabletták és kapszulák kényelmes megoldást kínálnak azok számára, akik nem szeretik a spirulina jellegzetes ízét, vagy egyszerűen csak gyorsan és pontosan szeretnék bevinni a napi adagot. Ezeket általában étkezés előtt, bő folyadékkal javasolt bevenni. A gyártó által javasolt adagolást mindig érdemes figyelembe venni, de általánosságban elmondható, hogy napi 3-6 tabletta vagy kapszula (az adagolástól függően) elegendő lehet.
Mindig figyeljünk a fokozatos bevezetésre, különösen, ha érzékeny az emésztőrendszerünk. Néhány embernél kezdetben enyhe emésztési zavarok, mint puffadás vagy enyhe hasmenés jelentkezhetnek, de ezek általában rövid időn belül elmúlnak, ahogy a szervezet alkalmazkodik. A bőséges folyadékfogyasztás szintén kulcsfontosságú a spirulina szedésekor, mivel segít a méregtelenítési folyamatokban.
Minőség és biztonság: Mire figyeljünk spirulina vásárlásakor?
Mivel a spirulina egy olyan mikroorganizmus, amely a vízből veszi fel a tápanyagokat, rendkívül fontos a termék minősége és tisztasága. A szennyezett vizekből származó spirulina nehézfémeket (ólom, higany, kadmium), peszticideket vagy mikrocisztineket (toxinok, amelyeket más kék-zöld algák termelhetnek) tartalmazhat, amelyek károsak lehetnek az egészségre.
A biztonságos és hatékony spirulina kiválasztásához az alábbi szempontokat érdemes figyelembe venni:
- Származási hely és termesztési körülmények: Válasszunk olyan terméket, amely ellenőrzött, tisztított forrásból származik, ideális esetben zárt rendszerekben vagy távoli, szennyezetlen területeken termesztik.
- Minőségi tanúsítványok: Keressük az olyan tanúsítványokat, mint az ISO 9001, HACCP, vagy a bio minősítés, amelyek garantálják a gyártási folyamat tisztaságát és a termék biztonságát.
- Nehézfém és toxin tesztek: A megbízható gyártók rendszeresen tesztelik termékeiket nehézfémekre és mikrocisztinekre, és ezekről a teszteredményekről gyakran tájékoztatást is adnak a weboldalukon vagy a csomagoláson.
- Adalékanyagok hiánya: Lehetőleg olyan terméket válasszunk, amely nem tartalmaz felesleges adalékanyagokat, töltőanyagokat, tartósítószereket vagy mesterséges színezékeket.
- Csomagolás: A spirulina érzékeny a fényre és a levegőre, ezért sötét, légmentesen záródó csomagolásban kell tárolni, hogy megőrizze hatóanyag-tartalmát.
Bár a spirulina általában biztonságosnak tekinthető, néhány esetben óvatosságra lehet szükség. Autoimmun betegségben szenvedőknek, terhes és szoptató nőknek, valamint bizonyos gyógyszereket szedőknek (különösen véralvadásgátlókat) javasolt konzultálniuk orvosukkal a spirulina szedése előtt.
Életmódváltás és a spirulina szinergikus hatása

Fontos hangsúlyozni, hogy a spirulina, akármilyen hatékony is, önmagában nem csodaszer, és nem helyettesítheti az egészséges életmódot. A vérnyomás tartós és hatékony csökkentéséhez, valamint az általános egészség megőrzéséhez komplex megközelítésre van szükség, amely magában foglalja az étrend, a testmozgás és a stresszkezelés optimalizálását.
A spirulina a legjobban egy kiegyensúlyozott étrenddel kombinálva fejti ki hatását. Ez magában foglalja a feldolgozott élelmiszerek, a túlzott só- és cukorbevitel csökkentését, valamint a friss zöldségek, gyümölcsök, teljes kiőrlésű gabonák és sovány fehérjék bőséges fogyasztását. Az olyan étrendek, mint a DASH (Dietary Approaches to Stop Hypertension) vagy a mediterrán diéta, kifejezetten a vérnyomás csökkentésére és a szív- és érrendszeri egészség támogatására lettek kifejlesztve, és kiváló alapot nyújtanak a spirulina beillesztéséhez.
A rendszeres testmozgás szintén elengedhetetlen. Napi 30 perc mérsékelt intenzitású fizikai aktivitás, mint például a gyors séta, úszás vagy kerékpározás, jelentősen hozzájárulhat a vérnyomás csökkentéséhez és a szív- és érrendszer erősítéséhez. A spirulina extra energiát és tápanyagokat biztosíthat, amelyek segítenek fenntartani az edzésprogramot és felgyorsítják a regenerációt.
Végül, de nem utolsósorban, a stresszkezelés kulcsfontosságú. A krónikus stressz emeli a kortizol szintjét, ami hosszú távon hozzájárulhat a magas vérnyomáshoz. Relaxációs technikák, mint a jóga, meditáció, légzőgyakorlatok vagy egyszerűen csak a természetben töltött idő, mind segíthetnek a stressz szintjének csökkentésében. A spirulina, mint adaptogén jellegű élelmiszer, támogathatja a szervezet stressztűrő képességét is, hozzájárulva a mentális és fizikai egyensúlyhoz.
A spirulina nem helyettesíti az orvosi tanácsot és kezelést, de kiváló kiegészítője lehet egy proaktív, egészségtudatos életmódnak, amely a természetes utakat is felhasználja a vérnyomás optimalizálásában.
Kinek ajánlott a spirulina vérnyomás optimalizálására?
A spirulina a vérnyomás optimalizálására számos ember számára hasznos lehet, de fontos hangsúlyozni, hogy minden esetben a személyes körülmények és az orvosi tanácsok figyelembevételével kell dönteni a szedéséről.
Ajánlott lehet azok számára, akik:
- Enyhén emelkedett vérnyomással küzdenek: Azoknak, akiknek vérnyomása a normál felső határán mozog, vagy enyhe hipertóniájuk van, és szeretnének természetes módszerekkel beavatkozni, mielőtt gyógyszeres kezelésre lenne szükség.
- Már gyógyszert szednek, de szeretnék kiegészíteni a terápiát: Orvosi felügyelet mellett a spirulina segíthet a gyógyszerek hatékonyságának támogatásában, vagy akár hosszú távon hozzájárulhat a gyógyszeradagok optimalizálásához (mindig orvosi konzultációval!).
- Túlsúlyosak vagy elhízottak: Mivel a spirulina segíthet a testsúlykontrollban, hasznos lehet azoknak, akiknek a magas vérnyomása a túlsúlyhoz kapcsolódik.
- Magas koleszterinszinttel rendelkeznek: Azok, akiknél a lipidprofil javítására van szükség, szintén profitálhatnak a spirulina koleszterinszint-csökkentő hatásából.
- Antioxidáns és gyulladáscsökkentő támogatást keresnek: Bárki, aki szeretné erősíteni szervezete védekezőképességét az oxidatív stressz és a krónikus gyulladás ellen, ami közvetetten a szív- és érrendszer egészségét is szolgálja.
- Vegetáriánusok vagy vegánok: Magas fehérje-, vas- és B-vitamin tartalma miatt kiváló táplálékkiegészítő lehet számukra, ami hozzájárul az általános vitalitáshoz és az érrendszeri egészséghez.
Mindig javasolt konzultálni egy háziorvossal vagy szakorvossal, mielőtt bármilyen új étrend-kiegészítőt bevezetnénk, különösen, ha valamilyen krónikus betegségben szenvedünk, vagy gyógyszereket szedünk. Az orvos segíthet felmérni az egyéni kockázatokat és előnyöket, és tanácsot adhat a megfelelő adagolással kapcsolatban.
A spirulina mint a hosszú távú egészség támogatója
A spirulina nem csupán egy pillanatnyi megoldás a magas vérnyomás problémájára, hanem egy olyan holisztikus élelmiszer, amely hosszú távon képes támogatni a szervezet egészségét és vitalitását. Gazdag tápanyagprofiljának, erőteljes antioxidáns és gyulladáscsökkentő hatásainak, valamint az érrendszeri funkciókra gyakorolt pozitív befolyásának köszönhetően méltán érdemli ki a „szuperélelmiszer” címet.
A vérnyomás optimális szinten tartása nem egy egyszeri feladat, hanem egy folyamatos, tudatos erőfeszítés, amely magában foglalja az egészséges életmódra való törekvést és a szervezetünk igényeinek figyelembevételét. A spirulina beépítése ebbe a folyamatba egy értelmes és hatékony lépés lehet, amely hozzájárulhat ahhoz, hogy hosszú távon megőrizzük szívünk és érrendszerünk egészségét, és élvezhessük a teljes, energikus életet.
A természetes megoldások ereje gyakran abban rejlik, hogy nem csupán egy tünetet kezelnek, hanem az egész szervezetre jótékony hatást gyakorolnak, segítve az egyensúly helyreállítását. A spirulina pontosan ilyen, egy apró, mégis hatalmas erővel bíró ajándék a természettől, amely támogatja testünk öngyógyító képességét és hozzájárul a hosszú, egészséges élethez.


